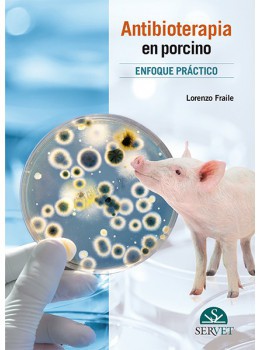
Antibioterapia En Porcino

Medicina
Antibioterapia En Porcino
| En este libro sobre antibioterapia práctica en la especie porcina, el autor presenta, de forma práctica y desde una perspectiva actualizada, los aspectos más importantes que un veterinario clínico debería tener en cuenta para diseñar tratamientos antimicrobianos adecuados en cerdos. Esta revisión de los conocimientos actuales en farmacología se acompaña de casos clínicos reales resueltos por el autor, siempre bajo la premisa de que el uso prudente de los antibióticos es esencial para prevenir la aparición de resistencias. |
-
Especialidad
- Medicina Interna en Pequeños y Grandes
-
Información general
- Formato Impreso
- Acabado Tapa Dura
- Año de publicación 2016
- Editorial Servet
- Autor Sauce, F.
- Páginas 168
- ISBN 9788416315840
- Edición 4ª
| En este libro sobre antibioterapia práctica en la especie porcina, el autor presenta, de forma práctica y desde una perspectiva actualizada, los aspectos más importantes que un veterinario clínico debería tener en cuenta para diseñar tratamientos antimicrobianos adecuados en cerdos. Esta revisión de los conocimientos actuales en farmacología se acompaña de casos clínicos reales resueltos por el autor, siempre bajo la premisa de que el uso prudente de los antibióticos es esencial para prevenir la aparición de resistencias. |
Escribir Su propia reseña
Productos relacionados
-
 Enfermedad Psoriásica
Enfermedad PsoriásicaNovedad
Año: 2026 Autores: Fernández, D.Precio Celsus COP $121.000 Precio Lista COP $142.000
-
 Netter. Anatomía de cabeza y cuello para odontólogos
Netter. Anatomía de cabeza y cuello para odontólogosNovedad
Futura publicación
Año: 2026 Autores: Norton, N.Precio Lista COP $0
Agotado -
 Inmunología 10ª Ed.
Inmunología 10ª Ed.Novedad
Futura publicación
Año: 2026 Autores: Male, D.Precio Lista COP $0
Agotado -
 Principios de neurociencia
Principios de neurocienciaNovedad
Futura publicación
Año: 2026 Autores: Haines, D.Precio Lista COP $0
Agotado -
 Inmunología veterinaria 11ª Ed.
Inmunología veterinaria 11ª Ed.Novedad
Futura publicación
Año: 2026 Autores: Tizard, I.Precio Lista COP $0
Agotado -
 Firestein y Kelley. Tratado de reumatología 2 Volumenes
Firestein y Kelley. Tratado de reumatología 2 VolumenesNovedad
Futura publicación
Año: 2026 Autores: Firestein, G.Precio Lista COP $0
Agotado -
 Cirugía de Catarata
Cirugía de CatarataNovedad
Año: 2026 Autores: Castillejos, D.Precio Celsus COP $183.000 Precio Lista COP $215.000
-
 Patología del Tracto Genital Inferior
Patología del Tracto Genital InferiorNovedad
Año: 2026 Autores: Orozco, R.Precio Celsus COP $243.000 Precio Lista COP $286.000
-
 Manual Washington de cirugía 9ª
Manual Washington de cirugía 9ªNovedad
Futura publicación
Año: 2026 Autores: Wise, P.Precio Lista COP $0
Agotado -
 Serie RT. Farmacología
Serie RT. FarmacologíaNovedad
Futura publicación
Año: 2026 Autores: Lerchenfeldt S,Precio Lista COP $0
Agotado -
 Anatomía y protocolos de bolsillo para ecografía ginecológica y obstétrica
Anatomía y protocolos de bolsillo para ecografía ginecológica y obstétricaNovedad
Futura publicación
Año: 2026 Autores: Penny, S.Precio Lista COP $0
Agotado -
 Nefrología de bolsillo 2ª. Ed
Nefrología de bolsillo 2ª. EdNovedad
Futura publicación
Año: 2026 Autores: Wooin A,Precio Lista COP $0
Agotado
